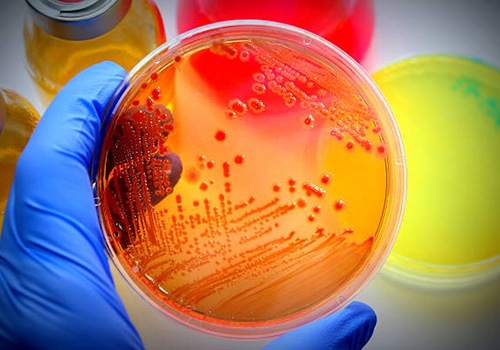

TRIOS LABORATOIRE D'ANALYSES MEDICALES
Vous êtes ici sur le site Internet de TRIOS Laboratoire d’Analyses Médicales, TLAM en sigle.
TLAM est un laboratoire polyvalent créé en septembre 2018 sous l’égide de l’Association TRIOS. Cette dernière fut créée le 13 mars 2018 par des biologistes hospitaliers formés à la Faculté des Sciences de la Santé (FSSA) de l’Université Marien NGOUABI du Congo Brazzaville et a été officiellement déclarée le 23 avril 2018 sous le numéro 108/18 MID/DBZV/SG/DDAT/SR. TLAM est dirigé par des biologistes hospitaliers tous actuellement inscrits en thèse à la FSSA dans différents domaines de la biologie médicale.
TRIOS Laboratoire d’Analyses Médicales est un laboratoire spécialisé dans les actes de biologie médicale. Notre équipe de professionnels dévoués assure une prise en charge complète et de qualité pour les patients en ambulatoire ainsi que pour différents établissements de soins, 24 heures sur 24 et 365 jours par an, y compris dans des situations d’urgence.
En savoir plusNOS COMPETENCES
Les Sciences Biomédicales, notre cœur de métier : MICROBIOLOGIE, HORMONOLOGIE, HEMATOLOGIE, BIOLOGIE MOLECULAIRE et la BIOCHIMIE. Nous réalisons des examens d'analyses médicales dans trois grands domaines : la prévention, le diagnostic et le suivi, en étroite collaboration avec vos médecins, infirmières, sages-femmes.
MICROBIOLOGIE
c’est la branche de la biologie qui étudie les micro-organismes tels que les bactéries, les virus, les champignons et les parasites. Elle joue un rôle important dans le diagnostic et le traitement des infections.

HORMONOLOGIE
C’est la branche de la médecine qui se concentre sur l’étude du sang et de la moelle osseuse. Elle englobe la compréhension des cellules sanguines (globules rouges et blancs, plaquettes), les facteurs de coagulation, de la moelle osseuse et des maladies liées au sang telles que l’anémie, la leucémie et les troubles de la coagulation.

HEMATOLOGIE
L'hématologie est la spécialité médicale s'intéressant aux éléments constituant le sang (globules rouges et blancs, plaquettes sanguines…), la lymphe et les organes les sécrétant (moelle osseuse, rate, amygdales) ainsi qu'aux maladies qui y sont liées.

BIOLOGIE MOLECULAIRE
C’est une branche de la biologie qui se concentre sur l’étude des processus biologique au niveau moléculaire. Elle vise à comprendre les mécanismes moléculaires tels que l’ADN et l’ARN.

BIOCHIMIE
C’est une discipline scientifique qui se concentre sur l’analyse des composants chimiques du sang.

REPRODUCTION
Est une branche de la biologie ayant pour objet l'analyse des liquides seminaux dans le but de diagnostiquer les pathologies ...
Notre équipe
LE MIEUX FAIRE DANS LA MODERNISATION

Berge TSIBA NGOKANA
PhD Student- UMNG
Brel Emmanuel GOT
PhD Student- UMNG
Rod IBARA OKABANDE
PhD Student- UMNG
Bernaud Sedwige LOUNGOUALA SOUNDA
PhD Student- UMNG
Aymard Landry LOUKANOU
PhD Student- UMNG
Judicael FOUNDIKILA M.
Responsable du Plateau Technique
Daphnée SITA N.
Coordonnatrice du Plateau Technique
----------
Chargé de l'Assurance Qualité
--------------
------------TRIOS LABORATOIRE
Le mieux faire dans la nouvelle gestion
Nos partenaires
Ils nous font confiances.







